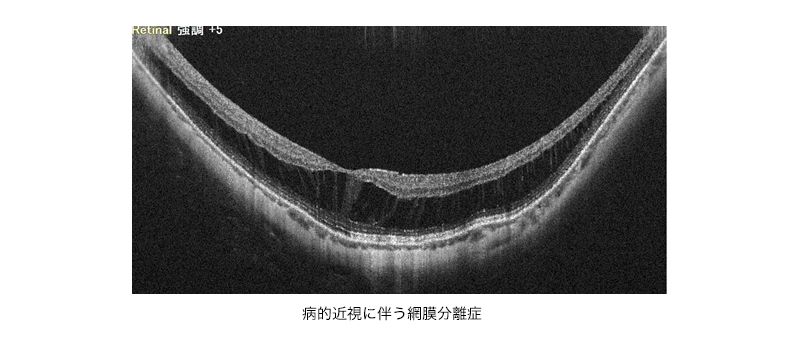

網膜硝子体疾患、最新の白内障手術なら札幌中央区の眼科 おくしば眼科へ
おくしば眼科
〒060-0011札幌市中央区北11条西14丁目1-1ほくやくビル2F
| 診療時間 | 月 | 火 | 水 | 木 | 金 | 土・日・祝 |
|---|---|---|---|---|---|---|
| 9:00〜12:00 | ● | ● | ● | ● | ● | 休 |
| 14:00〜17:00 | ● | 手術 | ● | - | ● | 休 |
ご予約はこちら 011-707-8181 011-707-8186
診療内容 -強度近視(病的近視)-

おくしば眼科
〒060-0011札幌市中央区北11条西
14丁目1-1 ほくやくビル2F
(1Fにパルス薬局がございます)
011-707-8181 011-707-8186

| 診療時間 | 月 | 火 | 水 | 木 | 金 |
|---|---|---|---|---|---|
| 9:00〜 12:00 | ● | ● | ● | ● | ● |
| 14:00〜 17:00 | ● | 手術 | ● | - | ● |
※土日祝は休診となりますので、ご了承ください。

診療のご案内

・強度近視(病的近視)について
強度近視とは-8D(ジオプター)以上の近視で、眼の前後の長さが伸びて、網膜や脈絡膜が後方に引き伸ばされ負荷が増強します。
網膜や脈絡膜に負荷がかかることで、その後部に変形が起き(後部ぶどう腫)、眼底にさまざまな異常が生じた強度近視を病的近視と呼びます。
網膜や脈絡膜に負荷がかかることで、その後部に変形が起き(後部ぶどう腫)、眼底にさまざまな異常が生じた強度近視を病的近視と呼びます。

・網膜静脈閉塞症の検査
1)網脈絡膜萎縮
眼軸の伸展により、脈絡膜が菲薄化し、脈絡膜、網膜が障害されて萎縮する病態です。黄斑部に局在性萎縮が進行すると、視力が著しく低下します。
眼軸の伸展により、脈絡膜が菲薄化し、脈絡膜、網膜が障害されて萎縮する病態です。黄斑部に局在性萎縮が進行すると、視力が著しく低下します。

2)近視性牽引黄斑症
強度近視により眼球の壁が引き伸ばされた状態で、黄斑の網膜にすきまができたり(黄斑分離)、はがれたり(黄斑剥離)して、視力が低下します。進行して黄斑に孔があくと(黄斑円孔)、網膜剥離が悪化します。黄斑剥離が生じたら、硝子体手術を 行います。
強度近視により眼球の壁が引き伸ばされた状態で、黄斑の網膜にすきまができたり(黄斑分離)、はがれたり(黄斑剥離)して、視力が低下します。進行して黄斑に孔があくと(黄斑円孔)、網膜剥離が悪化します。黄斑剥離が生じたら、硝子体手術を 行います。
3)近視性脈絡膜新生血管(病的近視における脈絡膜新生血管)
黄斑部の網膜が引き伸ばされて亀裂が生じ、本来血管のない黄斑部に、脈絡膜から新しい血管(脈絡膜新生血管)が伸びてくる病気です。新生血管はもろいため出血しやすく、出血すると視力低下やゆがみなどの症状が出ます。 病的近視の約10%に生じます。
黄斑部の網膜が引き伸ばされて亀裂が生じ、本来血管のない黄斑部に、脈絡膜から新しい血管(脈絡膜新生血管)が伸びてくる病気です。新生血管はもろいため出血しやすく、出血すると視力低下やゆがみなどの症状が出ます。 病的近視の約10%に生じます。
・近視性脈絡膜新生血管の検査
①眼底検査
網膜の血管の状態、出血や黄斑浮腫の状態を見ることができます。
網膜の血管の状態、出血や黄斑浮腫の状態を見ることができます。

②蛍光眼底造影
蛍光色素の入った造影剤を腕の静脈から注射して、眼底カメラで眼底の血管を観察します。新生血管からの蛍光漏出が観察できます。
蛍光色素の入った造影剤を腕の静脈から注射して、眼底カメラで眼底の血管を観察します。新生血管からの蛍光漏出が観察できます。

③光干渉断層計(OCT検査)
網膜は層構造になっており、その層構造を断面的に観察する検査です。
脈絡膜新生血管や浮腫の状態がわかります。
網膜は層構造になっており、その層構造を断面的に観察する検査です。
脈絡膜新生血管や浮腫の状態がわかります。

・近視性脈絡膜新生血管の治療
新生血管の成長を抑える抗VEGF剤を硝子体注射します。
病的近視による新生血管は比較的小さいため、1回の注射で新生血管が小さくなる方が約半数です。経過を見ながら、再発時には注射を追加します。
病的近視による新生血管は比較的小さいため、1回の注射で新生血管が小さくなる方が約半数です。経過を見ながら、再発時には注射を追加します。
Copyright(C)okushiba_eyeclinic_All Rights Reserved.
